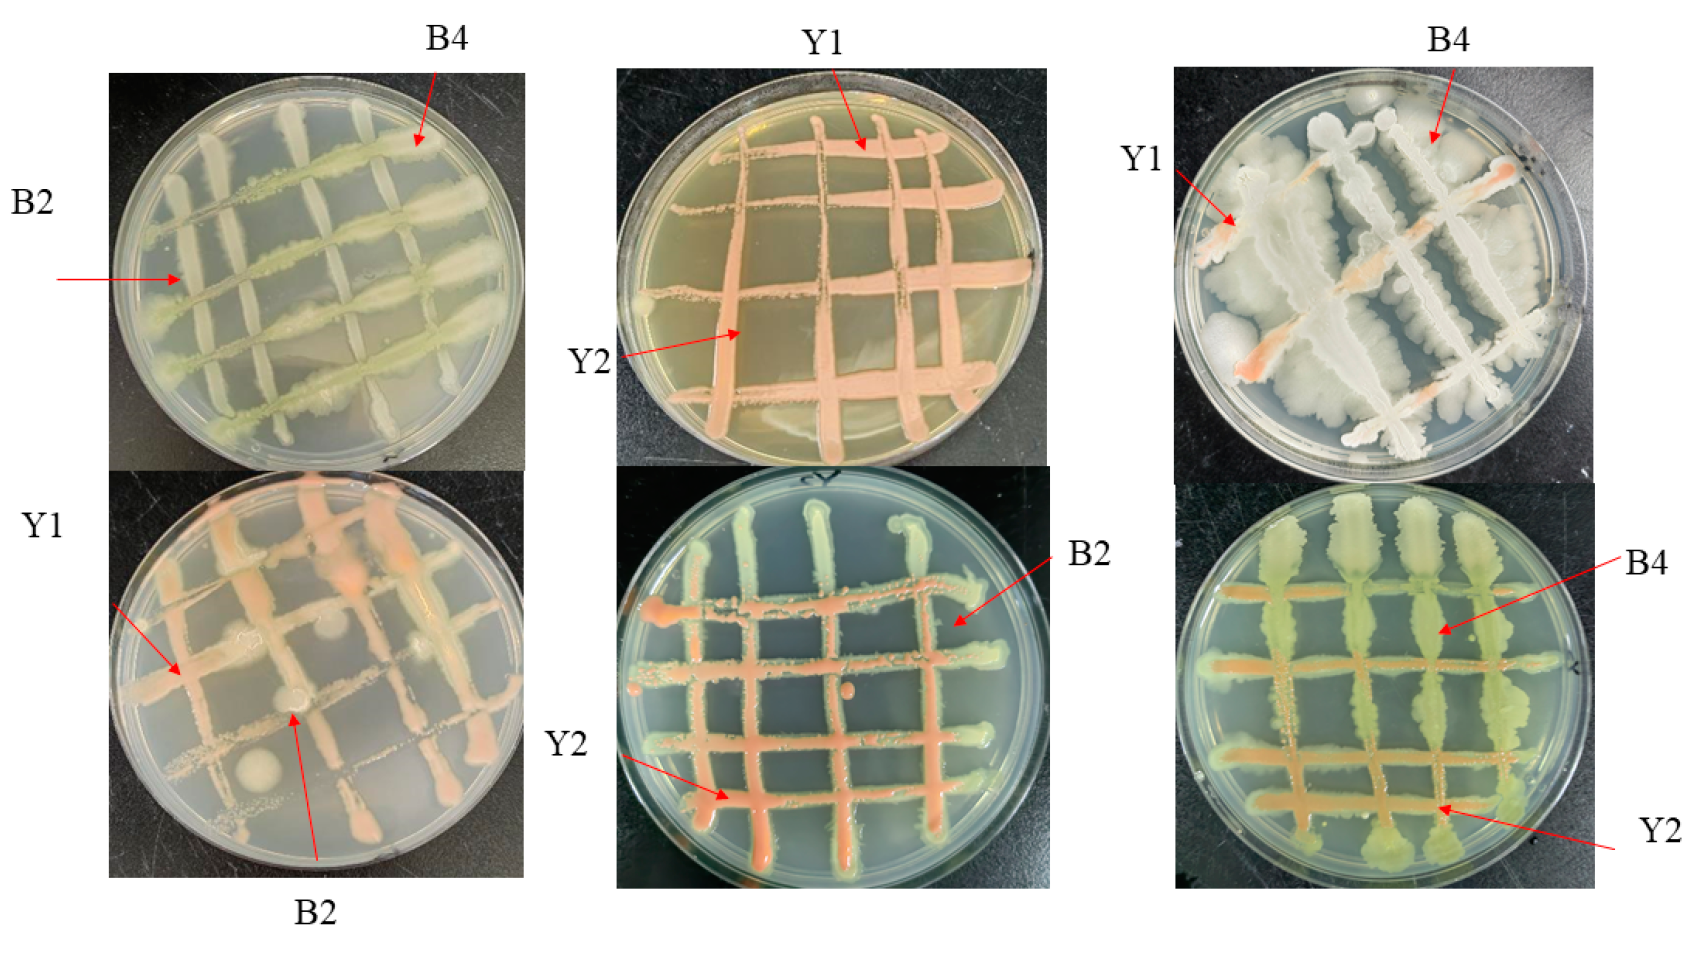
Foods 14 00408 g001

Construction of Composite Microorganisms and Their Physiological Mechanisms of Postharvest Disease Control in Red Grapes
Abstract
1. Introduction
2. Materials and Methods
2.1. Grapes
2.2. Pathogens
2.3. Antagonistic Microbes
2.4. Construction of Composite Strains
2.4.1. Affinity Test Between Strains
2.4.2. Best Ratio of Composite Microorganism with Inhibitory Effect on Blue Mold
2.4.3. Determination of Optimal Composite Ratio
2.5. Effect of Composite Microorganisms on Spore Germination Rate and Germ Tube Length of P. expansum and A. niger
2.6. Control of Red Grape Diseases by Volatile Metabolites Produced by Composite Microorganisms
2.6.1. Inhibitory Effect of Volatile Metabolites Produced by Composite Microorganisms on Growth of Pathogens
2.6.2. Effectiveness of Volatile Metabolites Produced by Composite Microorganisms Against Postharvest Blue Mold and Black Mold of Red Grapes
2.6.3. Analysis of Volatile Metabolite Fractions Produced by Composite Microorganisms
2.7. Control of Red Grape Diseases by Non-Volatile Metabolites Produced by Composite Microorganisms
2.7.1. Inhibitory Effect of Non-Volatile Metabolites Produced by Complex Microorganisms on Growth of P. expansum and A. niger
2.7.2. Effectiveness of Non-Volatile Metabolites Produced by Composite Microorganisms Against Postharvest Blue Mold and Black Mold of Red Grapes
2.8. Effect of Complex Microorganism W3 on Resistant Substances in Red Grapes
2.8.1. The Effect of Complex Microorganism W3 on the Metabolism of Active Oxygen in Red Grapes
2.8.2. Effect of Complex Microorganism W3 on Peroxidase (POD), Superoxide Dismutase (SOD), and Catalase (CAT) Activities of Red Grapes
2.9. Effect of Composite Microorganism W3 on Resistance-Related Substances and Enzyme Activities of Red Grapes
2.9.1. Effect of Composite Microorganism W3 on Activities of Polyphenol Oxidase (PPO), Ascorbate Peroxidase (APX), and Phenylalanine Ammonia-Lyase (PAL) in Red Grapes
2.9.2. Effect of Complex Microorganism W3 on Total Phenolic and Flavonoid Contents of Red Grapes
2.10. Data Analysis
3. Results
3.1. Construction of Composite Microbial Strains
3.1.1. Affinity Experiment Between Antagonist Strains
3.1.2. Construction of Optimal Ratio of Composite Microorganisms with Inhibitory Effects on P. expansum of Red Grapes
3.1.3. Construction of Optimal Ratio of Composite Microorganisms with Inhibitory Effect on A. niger of Red Grapes
3.1.4. Determination of Final Composite Ratio
3.2. Effect of Composite Microorganisms on Spore Germination Rate and Germ Tube Length of Pathogens
3.3. Control of Red Grapes by Volatile Metabolites Produced by Composite Microorganisms
3.3.1. Curbing Action of Volatile Excretions Produced by Composite Microorganisms on Growth of Pathogens
3.3.2. Efficacy of Volatile Compounds from Composite Microorganisms in Managing Postharvest Blue Mold and Black Mold on Red Grapes
3.3.3. Analysis of Volatile Metabolite Produced by Composite Microorganisms
3.4. Effects of Non-Volatile Metabolites Produced by Complex Microorganisms on Postharvest Diseases of Red Grape
3.4.1. Suppression of P. expansum and A. niger Growth by Non-Volatile Metabolites Generated by Composite Microorganisms
3.4.2. The Impact of Non-Volatile Metabolites Produced as a Result of Composite Microorganisms on the Prevention of Blue Mold and Black Mold in Red Grapes
3.5. Effect of Complex Microorganism W3 on POD, SOD, and CAT Activities of Red Grapes
3.6. Effects of Complex Microorganism W3 on Resistance-Related Substances and Enzyme Activity of Red Grapes
3.6.1. Effects of Complex Microorganism W3 on PPO, APX, and PAL Activities of Red Grapes
3.6.2. Effects of Complex Microorganism W3 on Total Phenol and Flavonoid Contents of Red Grapes
4. Discussion
5. Conclusions
Author Contributions
Funding
Data Availability Statement
Conflicts of Interest
References
- Kgang, I.E.; Klein, A.; Husselmann, L.; Nkomo, A.; Mathabe, P.M.K.; Belay, Z.A.; Caleb, O.J. Bioassays and proteomics as early detection tools in postharvest management of table grapes (Vitis vinifera L.) diseases—A Review. Food Biosci. 2023, 53, 102645. [Google Scholar] [CrossRef]
- Zhao, Y.; Jin, Q.; Wang, Z.J.; Tao, X.-Y.; Luo, X.-D. Quality assurance of postharvest grapes against Botrytis cinerea by terbinafine. Nat. Prod. Bioprospecting 2023, 13, 25. [Google Scholar] [CrossRef]
- Shao, W.Y.; Zhao, Y.F.; Ma, Z.H. Advances in Understanding Fungicide Resistance in Botrytis cinerea in China. Phytopathology 2021, 111, 455–463. [Google Scholar] [CrossRef] [PubMed]
- Romanazzi, G.; Smilanick, J.L.; Feliziani, E.; Droby, S. Integrated management of postharvest gray mold on fruit crops. Postharvest Biol. Technol. 2016, 113, 69–76. [Google Scholar] [CrossRef]
- Romanazzi, G.; Lichter, A.; Gabler, F.M.; Smilanick, J.L. Recent advances on the use of natural and safe alternatives to conventional methods to control postharvest gray mold of table grapes. Postharvest Biol. Technol. 2012, 63, 141–147. [Google Scholar] [CrossRef]
- Smilanick, J.L. Postharvest Diseases of Fruits and Vegetables: Development and Control. Postharvest Biol. Technol. 2004, 31, 213. [Google Scholar] [CrossRef]
- Dal Bello, G.; Monaco, C.M.; Rollan, M.C.; Lampugnani, G.; Arteta, N.; Abramoff, C.; Ronco, L.; Stocco, M. Biocontrol of postharvest grey mould on tomato by yeasts. J. Phytopathol. 2008, 156, 257–263. [Google Scholar] [CrossRef]
- Mussagy, C.U.; Ribeiro, H.F.; Pereira, J.F.B. Chapter Four—Rhodotorula sp. as a cell factory for production of valuable biomolecules. In Advances in Applied Microbiology; Makowski, G.S., Sariaslani, S., Eds.; Academic Press: Cambridge, MA, USA, 2023; pp. 133–156. [Google Scholar]
- Nikanova, D.A.; Kolodina, E. Influence of living yeast of the genus Rhodotorula against probiotic and pathogenic bacteria. J. Anim. Sci. 2020, 98, 414. [Google Scholar] [CrossRef]
- Mathew, L.; Salustra, U.; Cheryl, S.; Bonnee, R. The Oleaginous Red Yeast Rhodotorula/Rhodosporidium: A Factory for Industrial Bioproducts. In Yeasts in Biotechnology; Thalita Peixoto, B., Ed.; IntechOpen: Rijeka, Croatia, 2019; Chapter 7. [Google Scholar]
- Li, Z.Y.; Li, J.J.; Yu, M.; Quandahor, P.; Tian, T.; Shen, T. Bacillus velezensis FX-6 suppresses the infection of Botrytis cinerea and increases the biomass of tomato plants. PLoS ONE 2023, 18, e0286971. [Google Scholar] [CrossRef]
- Zhang, X.; Zhou, Y.Y.; Li, Y.; Fu, X.C.; Wang, Q. Screening and characterization of endophytic Bacillus for biocontrol of grapevine downy mildew. Crop Prot. 2017, 96, 173–179. [Google Scholar] [CrossRef]
- Shafi, J.; Tian, H.; Ji, M.S. Bacillus species as versatile weapons for plant pathogens: A review. Biotechnol. Biotechnol. Equip. 2017, 31, 446–459. [Google Scholar] [CrossRef]
- Ongena, M.; Jacques, P. Bacillus lipopeptides: Versatile weapons for plant disease biocontrol. Trends Microbiol. 2008, 16, 115–125. [Google Scholar] [CrossRef] [PubMed]
- Zheng, M.; Shi, J.Y.; Shi, J.; Wang, Q.G.; Li, Y.H. Antimicrobial effects of volatiles produced by two antagonistic Bacillus strains on the anthracnose pathogen in postharvest mangos. Biol. Control 2013, 65, 200–206. [Google Scholar] [CrossRef]
- Ding, Y.; Wei, R.; Song, Y.; Li, H.; Wang, H. Research status of the diversity of natural microbial community and metabolic enzyme system in grape ecosystem. Microbiol. China 2021, 48, 2837–2852. [Google Scholar]
- Zhao, Y.; Li, J.; Xie, W.; Zhao, H. Microbial diversity of wine grape skins from four different regions in China. Food Ferment. Ind. 2021, 47, 53–60. [Google Scholar] [CrossRef]
- Che, J.; Lai, G.; Li, S.; Guo, A.; Chen, B.; Chen, X.; Liu, B.; Lai, C. Effects of Compound Microbial Agent on the Growth, Quality and Rhizosphere Environment of Grape. Biotechnol. Bull. 2024, 40, 264–274. [Google Scholar] [CrossRef]
- Shen, Y.C.; Korkor, N.L.; Xiao, R.; Pu, Q.; Hu, M.; Zhang, S.S.; Kong, D.D.; Zeng, G.H.; Hu, X.F. Antagonistic activity of combined bacteria strains against southern blight pathogen of Dendrobium officinale. Biol. Control 2020, 151, 104291. [Google Scholar] [CrossRef]
- Cai, X.Y.; Zhao, H.H.; Liang, C.; Li, M.; Liu, R.J. Effects and Mechanisms of Symbiotic Microbial Combination Agents to Control Tomato Fusarium Crown and Root Rot Disease. Front. Microbiol. 2021, 12, 629793. [Google Scholar] [CrossRef]
- Tian, Y.; Liu, Y.; Uwaremwe, C.; Zhao, X.; Yue, L.; Zhou, Q.; Wang, Y.; Tran, L.-S.P.; Li, W.; Chen, G.; et al. Characterization of three new plant growth-promoting microbes and effects of the interkingdom interactions on plant growth and disease prevention. Plant Cell Rep. 2023, 42, 1757–1776. [Google Scholar] [CrossRef] [PubMed]
- Srivastava, R.; Khalid, A.; Singh, U.S.; Sharma, A.K. Evaluation of arbuscular mycorrhizal fungus, fluorescent Pseudomonas and Trichoderma harzianum formulation against Fusarium oxysporum f. sp lycopersici for the management of tomato wilt. Biol. Control 2010, 53, 24–31. [Google Scholar] [CrossRef]
- Du, C.J.; Yang, D.; Ye, Y.F.; Pan, L.F.; Zhang, J.; Jiang, S.B.; Fu, G. Construction of a compound microbial agent for biocontrol against Fusarium wilt of banana. Front. Microbiol. 2022, 13, 1066807. [Google Scholar] [CrossRef]
- Zhu, M.R.; Yang, Q.Y.; Godana, E.A.; Huo, Y.N.; Hu, S.Y.; Zhang, H.Y. Efficacy of Wickerhamomyces anomalus in the biocontrol of black spot decay in tomatoes and investigation of the mechanisms involved. Biol. Control 2023, 186, 105356. [Google Scholar] [CrossRef]
- Zhou, Y.L.; Zhao, L.; Chen, Y.Q.; Dhanasekaran, S.; Chen, X.F.; Zhang, X.Y.; Yang, X.Z.; Wu, M.Y.; Song, Y.D.; Zhang, H.Y. Study on the control effect and physiological mechanism of Wickerhamomyces anomalus on primary postharvest diseases of peach fruit. Int. J. Food Microbiol. 2024, 413, 110575. [Google Scholar] [CrossRef]
- Shi, Y.; Zhao, Q.H.; Xin, Y.; Yang, Q.Y.; Dhanasekaran, S.; Zhang, X.Y.; Zhang, H.Y. Aureobasidium pullulans S2 controls tomato gray mold and produces volatile organic compounds and biofilms. Postharvest Biol. Technol. 2023, 204, 112450. [Google Scholar] [CrossRef]
- Xu, B.G.; Feng, M.; Chitrakar, B.; Wei, B.X.; Wang, B.; Zhou, C.S.; Ma, H.L.; Wang, B.; Chang, L.; Ren, G.Y.; et al. Selection of drying techniques for Pingyin rose on the basis of physicochemical properties and volatile compounds retention. Food Chem. 2022, 385, 132539. [Google Scholar] [CrossRef]
- Xiao, J.W.; Zhao, L.A.; Bai, Y.H.; Lin, R.L.; Ngea, G.L.N.; Dhanasekaran, S.; Li, B.; Gu, X.Y.; Zhang, X.Y.; Zhang, H.Y. Sporidiobolus pararoseus Y16 Gamma-aminobutyric acid Aspergillus tubingensis Biocontrol mechanism Grape. Biol. Control 2022, 169, 104900. [Google Scholar] [CrossRef]
- Zhang, X.Y.; Yue, Q.R.; Xin, Y.; Ngea, G.L.N.; Dhanasekaran, S.; Luo, R.J.; Li, J.; Zhao, L.N.; Zhang, H.Y. The biocontrol potentiality of Bacillus amyloliquefaciens against postharvest soft rot of tomatoes and insights into the underlying mechanisms. Postharvest Biol. Technol. 2024, 214, 112983. [Google Scholar] [CrossRef]
- Deng, J.; Li, W.Q.; Ma, D.A.T.; Liu, Y.; Yang, H.Y.; Lin, J.; Song, G.; Naik, N.; Guo, Z.H.; Wang, F. Synergistic effect of carboxymethylcellulose and Cryptococcus laurentii on suppressing green mould of postharvest grapefruit and its mechanism. Int. J. Biol. Macromol. 2021, 181, 253–262. [Google Scholar] [CrossRef] [PubMed]
- Godana, E.A.; Yang, Q.Y.; Zhang, X.Y.; Zhao, L.A.; Wang, K.L.; Dhanasekaran, S.; Mehari, T.G.; Zhang, H.Y. Biotechnological and Biocontrol Approaches for Mitigating Postharvest Diseases Caused by Fungal Pathogens and Their Mycotoxins in Fruits: A Review. J. Agric. Food Chem. 2023, 71, 17584–17596. [Google Scholar] [CrossRef] [PubMed]
- Kumar, A.P.; Swamy, J.S.; Shahanaz; Gouthami, P.; Santhoshini, C.N.R. A Review on Bio-Based Control of Post-Harvest Diseases. Int. J. Plant Soil Sci. 2023, 35, 212–222. [Google Scholar] [CrossRef]
- Zhang, Y.; Wang, X.Y.; Liang, S.B.; Shi, Y.Y.; Chen, X.L.; Liu, J.Y.; Wang, A.X. Fermentation Optimization, Fungistatic Effects and Tomato Growth Promotion of Four Biocontrol Bacterial Strains. Agriculture 2021, 11, 686. [Google Scholar] [CrossRef]
- Cheng, M.Z.; Meng, F.Y.; Lv, R.; Wang, P.W.; Wang, Y.Z.; Chen, X.L.; Wang, A.X. Postharvest preservation effect of composite biocontrol agent on tomatoes. Sci. Hortic. 2023, 321, 112344. [Google Scholar] [CrossRef]
- Rivas-Garcia, T.; Murillo-Amador, B.; Nieto-Garibay, A.; Rincon-Enriquez, G.; Chiquito-Contreras, R.G.; Hernandez-Montiel, L.G. Enhanced biocontrol of fruit rot on muskmelon by combination treatment with marine Debaryomyces hansenii and Stenotrophomonas rhizophila and their potential modes of action. Postharvest Biol. Technol. 2019, 151, 61–67. [Google Scholar] [CrossRef]
- Klein, M.N.; Kupper, K.C. Biofilm production by Aureobasidium pullulans improves biocontrol against sour rot in citrus. Food Microbiol. 2018, 69, 1–10. [Google Scholar] [CrossRef]
- Czarnecka, M.; Zarowska, B.; Polomska, X.; Restuccia, C.; Cirvilleri, G. Role of biocontrol yeasts Debaryomyces hansenii and Wickerhamomyces anomalus in plants’ defence mechanisms against Monilinia fructicola in apple fruits. Food Microbiol. 2019, 83, 1–8. [Google Scholar] [CrossRef]
- Di Francesco, A.; Ugolini, L.; Lazzeri, L.; Mari, M. Production of volatile organic compounds by Aureobasidium pullulans as a potential mechanism of action against postharvest fruit pathogens. Biol. Control 2015, 81, 8–14. [Google Scholar] [CrossRef]
- Tilocca, B.; Balmas, V.; Hassan, Z.U.; Jaoua, S.; Migheli, Q. A proteomic investigation of Aspergillus carbonarius exposed to yeast volatilome or to its major component 2-phenylethanol reveals major shifts in fungal metabolism. Int. J. Food Microbiol. 2019, 306, 108265. [Google Scholar] [CrossRef] [PubMed]
- Koilybayeva, M.; Shynykul, Z.; Ustenova, G.; Waleron, K.; Jonca, J.; Mustafina, K.; Amirkhanova, A.; Koloskova, Y.; Bayaliyeva, R.; Akhayeva, T.; et al. Gas Chromatography-Mass Spectrometry Profiling of Volatile Metabolites Produced by Some Bacillus spp. and Evaluation of Their Antibacterial and Antibiotic Activities. Molecules 2023, 28, 7556. [Google Scholar] [CrossRef] [PubMed]
- Ma, Y.; Wu, M.J.; Qin, X.J.; Dong, Q.L.; Li, Z.S. Antimicrobial function of yeast against pathogenic and spoilage microorganisms via either antagonism or encapsulation: A review. Food Microbiol. 2023, 112, 104242. [Google Scholar] [CrossRef] [PubMed]
- Hasanuzzaman, M.; Bhuyan, M.; Anee, T.I.; Parvin, K.; Nahar, K.; Al Mahmud, J.; Fujita, M. Regulation of Ascorbate-Glutathione Pathway in Mitigating Oxidative Damage in Plants under Abiotic Stress. Antioxidants 2019, 8, 384. [Google Scholar] [CrossRef]
- Huang, Y.; Sun, C.C.; Guan, X.N.; Lian, S.; Li, B.H.; Wang, C.X. Biocontrol efficiency of Meyerozyma guilliermondii Y-1 against apple postharvest decay caused by Botryosphaeria dothidea and the possible mechanisms of action. Int. J. Food Microbiol. 2021, 338, 108957. [Google Scholar] [CrossRef] [PubMed]
- Benbouguerra, N.; Richard, T.; Saucier, C.; Garcia, F. Voltammetric Behavior, Flavanol and Anthocyanin Contents, and Antioxidant Capacity of Grape Skins and Seeds during Ripening (Vitis vinifera var. Merlot, Tannat, and Syrah). Antioxidants 2020, 9, 800. [Google Scholar] [CrossRef] [PubMed]
- Gong, C.; Liu, Y.; Liu, S.-y.; Cheng, M.-z.; Zhang, Y.; Wang, R.-h.; Chen, H.-y.; Li, J.-f.; Chen, X.-l.; Wang, A.-x. Analysis of Clonostachys rosea-induced resistance to grey mould disease and identification of the key proteins induced in tomato fruit. Postharvest Biol. Technol. 2017, 123, 83–93. [Google Scholar] [CrossRef]

| Pathogenic Fungi | Antagonistic Microorganism | The Ratio of Optimal Biocontrol Effect | Complex Microorganism |
|---|---|---|---|
| P. expansum | Y1:B2 | 1:1 | W1 |
| Y2:W1 | 1:4 | W2 | |
| B4:W2 | 1:1 | W3 | |
| A. niger | Y1:B2 | 5:1 | Q1 |
| Y2:Q1 | 1:1 | Q2 | |
| B4:Q2 | 1:1 | Q3 |
| Volatile Compounds | CAS | Relative Peak Area Ratio (%) | Chemical Formula |
|---|---|---|---|
| Phenylethyl Alcohol | 1960/12/8 | 30.77 | C8H10O |
| Butanoic acid, 2−methyl− | 116−53−0 | 7.43 | C5H10O2 |
| Docosanoic acid, ethyl ester | 5908−87−2 | 4.63 | C24H48O2 |
| Butanoic acid, 2−methyl−, ethyl ester | 7452−79−1 | 4.28 | C7H14O2 |
| 1−Butanol, 3−methyl−, acetate | 123−92−2 | 3.88 | C7H14O2 |
| Eicosyl isopropyl ether | 0−0−0 | 3.13 | C6H14O |
| 1−Propanol, 2,2−dimethyl−, acetate | 926−41−0 | 2.86 | C7H12O4 |
| Ethyl 13−methyl−tetradecanoate | 0−0−0 | 1.85 | C16H32O2 |
| 1−Propanol, 2,2−dimethyl−, acetate | 926−41−0 | 2.86 | C7H12O4 |
| Nonane, 5−(2−methylpropyl)− | 62185−53−9 | 1.81 | C13H28 |
| 2−Methoxy−4−vinylphenol | 7786−61−0 | 1.58 | C9H10O2 |
| Phthalan | 496−14−0 | 1.41 | C8H8O |
| 1,4−Butanediamine, 2,3−dimethoxy−N,N,N’,N’−tetramethyl−, [S−(R*,R*)]− | 26549−21−3 | 1.04 | C12H23BN2O4 |
Disclaimer/Publisher’s Note: The statements, opinions and data contained in all publications are solely those of the individual author(s) and contributor(s) and not of MDPI and/or the editor(s). MDPI and/or the editor(s) disclaim responsibility for any injury to people or property resulting from any ideas, methods, instructions or products referred to in the content. |
© 2025 by the authors. Licensee MDPI, Basel, Switzerland. This article is an open access article distributed under the terms and conditions of the Creative Commons Attribution (CC BY) license (https://creativecommons.org/licenses/by/4.0/).
Share and Cite
Chen, J.; Wang, K.; Godana, E.A.; Solairaj, D.; Yang, Q.; Zhang, H. Construction of Composite Microorganisms and Their Physiological Mechanisms of Postharvest Disease Control in Red Grapes. Foods 2025, 14, 408. https://doi.org/10.3390/foods14030408
Chen J, Wang K, Godana EA, Solairaj D, Yang Q, Zhang H. Construction of Composite Microorganisms and Their Physiological Mechanisms of Postharvest Disease Control in Red Grapes. Foods. 2025; 14(3):408. https://doi.org/10.3390/foods14030408
Chicago/Turabian StyleChen, Jingwei, Kaili Wang, Esa Abiso Godana, Dhanasekaran Solairaj, Qiya Yang, and Hongyin Zhang. 2025. "Construction of Composite Microorganisms and Their Physiological Mechanisms of Postharvest Disease Control in Red Grapes" Foods 14, no. 3: 408. https://doi.org/10.3390/foods14030408
APA StyleChen, J., Wang, K., Godana, E. A., Solairaj, D., Yang, Q., & Zhang, H. (2025). Construction of Composite Microorganisms and Their Physiological Mechanisms of Postharvest Disease Control in Red Grapes. Foods, 14(3), 408. https://doi.org/10.3390/foods14030408

